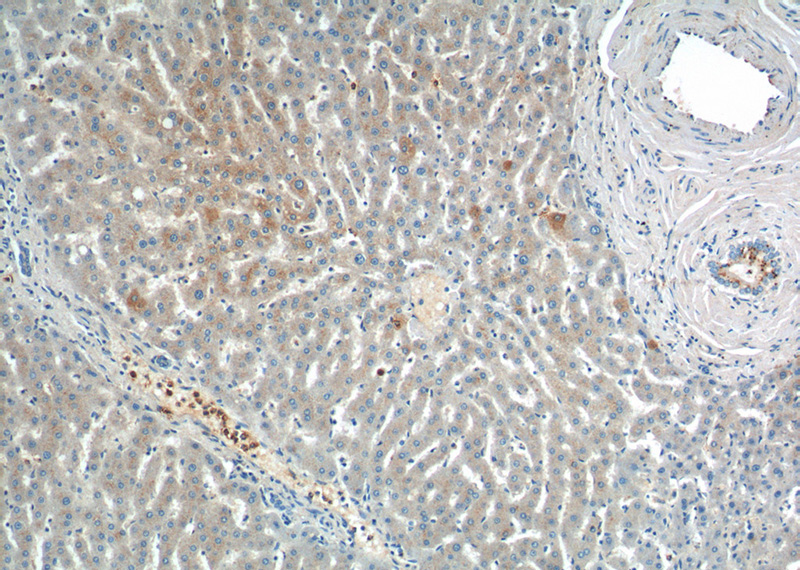
Immunohistochemistry of paraffin-embedded human liver tissue slide using Catalog No:111676(IGF1A-Specific Antibody) at dilution of 1:200 (under 10x lens).
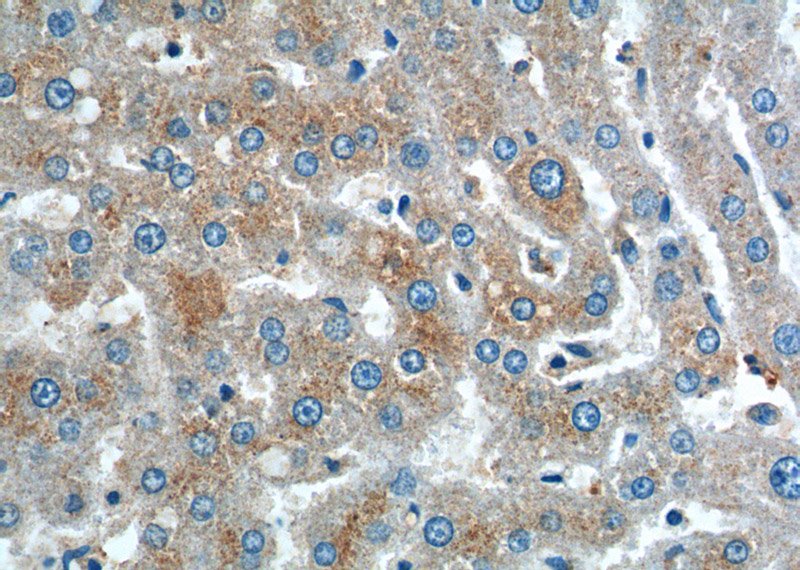
Immunohistochemistry of paraffin-embedded human liver tissue slide using Catalog No:111676(IGF1A-Specific Antibody) at dilution of 1:200 (under 40x lens).

-
Product Name
IGF1A-Specific antibody
- Documents
-
Description
IGF1A-Specific Rabbit Polyclonal antibody. Positive WB detected in mouse testis tissue, L02 cells, mouse liver tissue, mouse ovary tissue, mouse uterus tissue, PC-3 cells. Positive IP detected in mouse liver tissue. Positive IHC detected in human liver tissue, human liver cancer tissue. Positive IF detected in HepG2 cells, HeLa cells. Observed molecular weight by Western-blot: 15-20 kDa
-
Tested applications
ELISA, WB, IP, IF, IHC
-
Species reactivity
Human,Mouse,Rat; other species not tested.
-
Alternative names
IBP1 antibody; IGF I antibody; IGF1 antibody; IGF1A antibody; IGF1B antibody; IGFI antibody; Insulin like growth factor I antibody; Mechano growth factor antibody; MGF antibody; Somatomedin C antibody
-
Isotype
Rabbit IgG
-
Preparation
This antibody was obtained by immunization of Peptide. Purification method: Antigen affinity purified.
-
Clonality
Polyclonal
-
Formulation
PBS with 0.02% sodium azide and 50% glycerol pH 7.3.
-
Storage instructions
Store at -20℃. DO NOT ALIQUOT
-
Applications
Recommended Dilution:
WB: 1:200-1:2000
IP: 1:200-1:1000
IHC: 1:20-1:200
IF: 1:20-1:200
-
Validations

mouse testis tissue were subjected to SDS PAGE followed by western blot with Catalog No:111676(IGF1A-Specific antibody) at dilution of 1:500

IP Result of anti-IGF1A-Specific (IP:Catalog No:111676, 3ug; Detection:Catalog No:111676 1:300) with mouse liver tissue lysate 5000ug.
Immunohistochemistry of paraffin-embedded human liver tissue slide using Catalog No:111676(IGF1A-Specific Antibody) at dilution of 1:200 (under 10x lens).
Immunohistochemistry of paraffin-embedded human liver tissue slide using Catalog No:111676(IGF1A-Specific Antibody) at dilution of 1:200 (under 40x lens).

Immunofluorescent analysis of HepG2 cells using Catalog No:111676(IGF1A-Specific Antibody) at dilution of 1:50 and Alexa Fluor 488-congugated AffiniPure Goat Anti-Rabbit IgG(H+L)
-
Background
IGF1, also named as IBP1, MGF, IGF-IA and Somatomedin-C, belongs to the insulin family. IGF1 is structurally and functionally related to insulin but have a much higher growth-promoting activity. Altered expression or mutation of IGF-1 is associated with several human disorders, including type I diabetes and various forms of cancer. Defects in IGF1 are the cause of insulin-like growth factor I deficiency (IGF1 deficiency) which is an autosomal recessive disorder characterized by growth retardation, sensorineural deafness and mental retardation. The antibody is specific to isoform IGF-1A.
-
References
- Xu X, Hueckstaedt LK, Ren J. Deficiency of insulin-like growth factor 1 attenuates aging-induced changes in hepatic function: role of autophagy. Journal of hepatology. 59(2):308-17. 2013.
- Tang H, Liao Y, Xu L. Estrogen and insulin-like growth factor 1 synergistically promote the development of lung adenocarcinoma in mice. International journal of cancer. 133(10):2473-82. 2013.
- Hu Y, Liu W, Liu Z, Kuang W, He H. Receptor activator of nuclear factor-kappa ligand, OPG, and IGF-I expression during orthodontically induced inflammatory root resorption in the recombinant human growth hormone-treated rats. The Angle orthodontist. 85(4):562-9. 2015.
- Wen Y, Li J, Tan Y. Angelica Sinensis polysaccharides stimulated UDP-sugar synthase genes through promoting gene expression of IGF-1 and IGF1R in chondrocytes: promoting anti-osteoarthritic activity. PloS one. 9(9):e107024. 2014.
- Yuan L, Zhou C, Lu Y. IFN-γ-mediated IRF1/miR-29b feedback loop suppresses colorectal cancer cell growth and metastasis by repressing IGF1. Cancer letters. 359(1):136-47. 2015.
Related Products / Services
Please note: All products are "FOR RESEARCH USE ONLY AND ARE NOT INTENDED FOR DIAGNOSTIC OR THERAPEUTIC USE"
